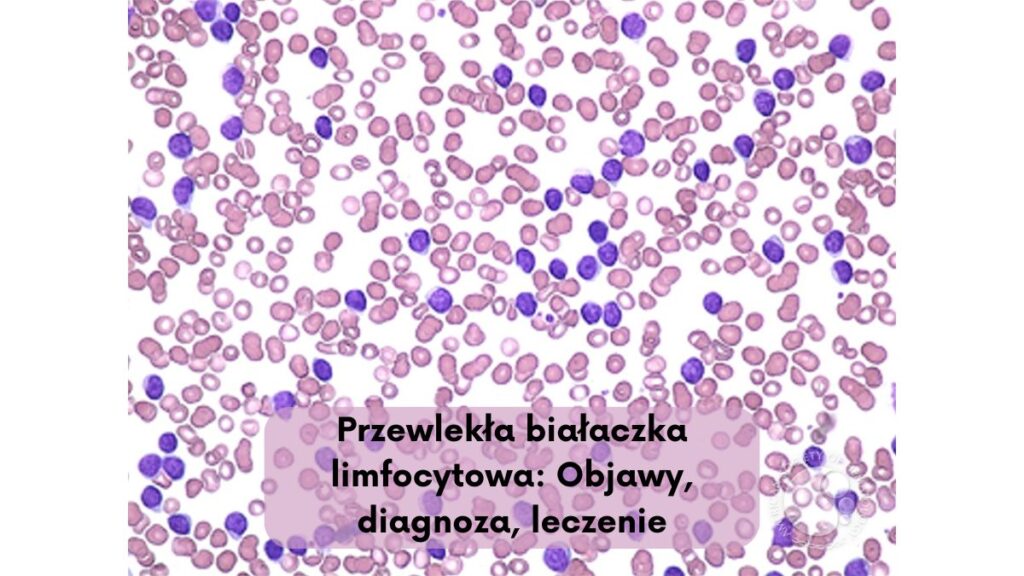
Przewlekła białaczka limfocytowa: Objawy, diagnoza, leczenie

I. Wprowadzenie
A. Co to jest przewlekła białaczka limfocytowa?
Przewlekła białaczka limfocytowa (PBL) to rodzaj raka krwi, który charakteryzuje się przewlekłym wzrostem limfocytów, czyli jednego rodzaju białych krwinek. Limfocyty są komórkami odpornościowymi, które pomagają organizmowi w walce z infekcjami. W PBL, limfocyty rozwijają się i rosną abnormale, co może prowadzić do powikłań zdrowotnych.

B. Dlaczego warto znać tę chorobę?
Ważne jest zrozumienie przewlekłej białaczki limfocytowej ze względu na jej potencjalne skutki zdrowotne. Wczesna diagnoza i leczenie PBL mogą pomóc w kontroli choroby i poprawie jakości życia pacjenta. Ponadto, świadomość tej choroby może pomóc w identyfikacji objawów i wyszukaniu pomocy medycznej w odpowiednim czasie.
II. Podstawowe informacje o PBL
A. Definicja i klasyfikacja PBL
Przewlekła białaczka limfocytowa (PBL) jest chorobą nowotworową układu krwiotwórczego, charakteryzującą się przewlekłym wzrostem dojrzałych limfocytów. Pod względem klasyfikacji, PBL jest zazwyczaj podzielona na dwie główne kategorie: typ klasyczny (CLL) oraz typ rzadki, niskojakościowy (SLL). Klasyfikacja ta uwzględnia różnice w agresywności i charakterze wzrostu komórek nowotworowych.
B. Jak rozwija się PBL?
Przyczyny rozwoju PBL nie są jeszcze do końca poznane, ale wiadomo, że jest to związane z mutacjami genetycznymi w limfocytach. W wyniku tych mutacji komórki limfocytów zaczynają się niekontrolowanie rozmnażać, co prowadzi do nadmiernego gromadzenia się dojrzałych limfocytów w organizmie.
C. Epidemiologia – kto jest narażony?
PBL jest częściej diagnozowana u osób starszych, zazwyczaj po 50. roku życia. Choroba rzadko występuje u osób młodych. Ponadto, pacjenci z historią rodzinną nowotworów krwi, palacze tytoniu oraz osoby narażone na promieniowanie jonizujące mogą być bardziej narażone na rozwój przewlekłej białaczki limfocytowej.
III. Przyczyny i czynniki ryzyka
A. Czynniki genetyczne i dziedziczność
Choć konkretna przyczyna PBL nie jest jeszcze w pełni zrozumiała, istnieje silny związek między czynnikami genetycznymi a ryzykiem rozwoju tej choroby. Pacjenci z historią rodzinną PBL mają większe ryzyko zachorowania, co sugeruje istnienie pewnych genetycznych predyspozycji do tej choroby.
B. Wpływ środowiska i stylu życia
Pojedyncze badania sugerują, że wystawienie na czynniki środowiskowe, takie jak ekspozycja na substancje chemiczne, promieniowanie jonizujące czy infekcje wirusowe, może zwiększać ryzyko rozwoju PBL. Ponadto, niektóre badania wskazują na potencjalny wpływ palenia tytoniu na zwiększenie ryzyka wystąpienia tej choroby.
C. Związki z innymi chorobami
PBL może występować w związku z innymi schorzeniami układu immunologicznego, takimi jak choroby autoimmunologiczne (np. toczeń rumieniowaty układowy, reumatoidalne zapalenie stawów). Osoby cierpiące na te choroby autoimmunologiczne mogą mieć wyższe ryzyko rozwoju PBL. Dodatkowo, istnieje również związki między PBL a innymi chorobami nowotworowymi, co sugeruje kompleksową interakcję między różnymi aspektami zdrowia pacjenta.
IV. Objawy Przewlekłej białaczki limfocytowej
A. Wczesne objawy – jak je rozpoznać?
W początkowych stadiach przewlekłej białaczki limfocytowej (PBL) objawy mogą być łagodne lub niespecyficzne, co sprawia, że diagnoza może być trudna. Wczesne objawy mogą obejmować:
- Powiększenie węzłów chłonnych, zwłaszcza szyjnych, pachwinowych i okołopłucnych.
- Zmęczenie i osłabienie.
- Możliwe nachodzenie plam krwi.
- Spożycie alkoholu powoduje dyskomfort w okolicach węzłów chłonnych.
- Wzrost infekcji bakteryjnych lub wirusowych.
B. Zaawansowane stadium – powikłania i symptomy
W miarę postępu choroby i przechodzenia do zaawansowanych stadiów PBL, objawy mogą ulec pogorszeniu, a mogą się pojawić również nowe symptomy. W zaawansowanym stadium PBL mogą wystąpić takie objawy i powikłania jak:
- Bardziej znaczne powiększenie węzłów chłonnych.
- Spadek masy ciała, utrata apetytu.
- Wysoka gorączka i nocne poty.
- Anemia z objawami związane z niedokrwistością, takimi jak osłabienie.
- Skłonność do krwawień i siniaki.
- Powikłania związane z układem krwiotwórczym, takie jak niedobór płytek krwi.
C. Różnice w przebiegu choroby u różnych pacjentów
Warto zauważyć, że przebieg PBL może być zróżnicowany, a objawy mogą się różnić w zależności od pacjenta. Niektórzy pacjenci mogą całe życie nie mieć żadnych objawów, a chorobę rozpoznaje się przypadkowo podczas rutynowych badań. Inni mogą doświadczać nagłego nasilenia objawów i komplikacji. Istnieją również różnice w odpowiedzi na leczenie i rokowanie między pacjentami z PBL, co podkreśla znaczenie indywidualnego podejścia do diagnozy i leczenia tej choroby.
V. Diagnostyka PBL
A. Badania laboratoryjne i wskaźniki diagnostyczne
Diagnostyka przewlekłej białaczki limfocytowej (PBL) opiera się na różnych badaniach laboratoryjnych i wskaźnikach diagnostycznych. Niektóre z nich mogą obejmować:
- Pełna morfologia krwi – podstawowe badanie, które pozwala zidentyfikować nieprawidłowości w komórkach krwi, takie jak zwiększona liczba limfocytów.
- Morfologia rozmazu krwi obwodowej – bardziej szczegółowe badanie mikroskopowe komórek krwi, które może ujawnić charakterystyczne cechy limfocytów PBL.
- Flow cytometria – technika pozwalająca na dokładne określenie podtypów krwinek białych na podstawie ich powierzchniowych markerów.
B. Biopsja szpiku – kiedy jest konieczna?
Biopsja szpiku kostnego jest często konieczna w procesie diagnostycznym PBL. Jest to procedura, podczas której pobiera się próbkę szpiku kostnego w celu zbadania komórek krwi. Wykonuje się ją w celu potwierdzenia diagnozy PBL oraz oceny stopnia zaawansowania choroby.
C. Nowoczesne metody diagnostyczne (np. FISH, PCR)
W diagnostyce PBL wykorzystuje się także nowoczesne metody molekularne, takie jak fluorescencyjna hybrydyzacja in situ (FISH) i reakcja łańcuchowa polimerazy (PCR). Metoda FISH pozwala na wykrycie specyficznych zmian genetycznych charakterystycznych dla PBL, natomiast PCR umożliwia identyfikację specyficznych sekwencji DNA związanych z chorobą.
Wykorzystanie tych zaawansowanych metod diagnostycznych umożliwia dokładniejsze określenie rodzaju PBL oraz jego cech, co ma kluczowe znaczenie dla odpowiedniego planowania leczenia i monitorowania choroby.
VI. Klasyfikacja i stadia zaawansowania PBL
A. Skala Rai – podział na etapy choroby
Skala Rai jest jednym z systemów klasyfikacji stosowanych do określenia zaawansowania Przewlekłej białaczki limfocytowej (PBL). Wyróżnia się w niej trzy główne etapy choroby:
- Stadium 0 – brak objawów
- Stadium I i II – obecność zwiększonej liczby limfocytów w krwi i/lub węzłach chłonnych, ale bez występowania objawów choroby
- Stadium III i IV – zaawansowana choroba, charakteryzująca się objawami ogólnymi, np. anemią, powiększeniem śledziony czy wątroby.
B. Skala Binet – system klasyfikacji
Skala Binet to kolejny system klasyfikacji PBL, który opiera się na ocenie liczby i lokalizacji powiększonych węzłów chłonnych, obecności splenomegalii oraz niedokrwistości. Klasyfikuje PBL w trzech głównych grupach:
- Stadium A – brak objawów ogólnych lub związanych z narządami
- Stadium B – obecność objawów ogólnych takich jak splenomegalia lub powiększone węzły chłonne, bez niedokrwistości
- Stadium C – obecność niedokrwistości (nieprawidłowych wartości hemoglobiny) z dodatkowymi objawami ogólnymi
C. Znaczenie klasyfikacji w prognozowaniu i leczeniu
Klasyfikacja i określenie zaawansowania PBL ma kluczowe znaczenie zarówno w prognozowaniu choroby, jak i planowaniu odpowiedniego leczenia. Pozwala lekarzom ocenić ryzyko postępu choroby, odpowiednio dostosować terapię oraz monitorować skuteczność leczenia.
Pacjenci w zaawansowanych stadiach PBL mogą wymagać bardziej agresywnych form terapii, natomiast wczesne stadia choroby mają zwykle lepsze rokowania. Dlatego sklasyfikowanie PBL zgodnie z systemem klasyfikacji, takim jak skala Rai czy Binet, jest niezbędne do zapewnienia właściwej opieki medycznej i optymalnych wyników terapeutycznych.
VII. Przebieg i rokowania
A. Czy PBL zawsze wymaga leczenia?
Nie zawsze. W przypadku Przewlekłej białaczki limfocytowej (PBL) nie zawsze konieczne jest natychmiastowe leczenie. W przypadku pacjentów bez objawów lub z niskim ryzykiem nawrotu, lekarze mogą zdecydować się na ścisłe monitorowanie stanu zdrowia pacjenta (tzw. „obserwacja czynna”). Jeśli jednak choroba postępuje lub powoduje objawy, zalecane jest zastosowanie terapii.
B. Jakie są możliwe scenariusze rozwoju choroby?
- Stabilny przebieg – u niektórych pacjentów PBL może prowadzić do długotrwałego okresu stabilności, bez konieczności leczenia.
- Progresja choroby – w innych przypadkach PBL może prowadzić do narastających objawów, które wymagają interwencji terapeutycznej.
- Transformacja – u niektórych pacjentów PBL może ulec transformacji do bardziej agresywnych postaci białaczki, takich jak białaczka chłoniakowa.
C. Czynniki wpływające na długość życia pacjentów
- Stadium choroby – pacjenci w wczesnych stadiach PBL mają zazwyczaj lepsze rokowania niż ci w zaawansowanych stadiach choroby.
- Zmiany genetyczne – niektóre mutacje genetyczne mogą wpływać na agresywność choroby i rokowania pacjenta.
- Odpowiedź na terapię – skuteczność terapii może mieć znaczący wpływ na rokowania, dlatego monitorowanie reakcji na leczenie jest istotne dla prognozy.
- Wiek pacjenta – starsi pacjenci mogą mieć gorsze rokowania ze względu na ogólną kondycję zdrowotną i tolerancję leczenia.
- Obecność dodatkowych chorób czy powikłań – choroby współistniejące mogą pogorszyć rokowania pacjenta z PBL.
VIII. Możliwości leczenia
A. Obserwacja bez interwencji – kiedy wystarcza?
Obserwacja bez interwencji, czyli tzw. „obserwacja czynna”, może być zalecana u pacjentów z Przewlekłą białaczką limfocytową (PBL) w przypadku braku objawów choroby lub obecności niewielkiego ryzyka nawrotu. Ta strategia może być stosowana u pacjentów w wczesnych stadiach PBL, które nie wymagają natychmiastowego leczenia.
B. Farmakoterapia – najczęściej stosowane leki
Najczęściej stosowane leki w leczeniu Przewlekłej białaczki limfocytowej (PBL) to:
- Inhibitory kinazy BTK (np. Ibrutinib) – blokują one kinazę Brutona (BTK), co prowadzi do zatrzymania wzrostu komórek białaczkowych.
- Inhibitory BCL-2 (np. Venetoclax) – działają poprzez zahamowanie białka BCL-2, które pomaga komórkom nowotworowym unikać apoptozy.
- Antyciała monoklonalne (np. Rituximab, Obinutuzumab) – wykazują zdolność do precyzyjnego ataku na komórki nowotworowe, niszcząc je bez uszkodzenia zdrowych komórek.
C. Chemioterapia – wskazania i skuteczność
Chemioterapia może być wskazana w przypadku PBL jako:
- Leczenie pierwszorzutowe – w niektórych przypadkach może być stosowana, zwłaszcza u pacjentów z agresywną postacią choroby.
- Terapia skojarzona – może być stosowana w połączeniu z innymi lekami, takimi jak immunoterapia, aby zwiększyć skuteczność leczenia.
- Leczenie ratunkowe – może być stosowane u pacjentów, którzy nie reagują na inne formy terapii.
Skuteczność chemioterapii w PBL może być różna w zależności od indywidualnego przypadku, stadium choroby i czynników prognostycznych. Lekarz decyduje o zastosowaniu odpowiedniej terapii, biorąc pod uwagę specyficzne warunki pacjenta oraz cechy jego choroby.
IX. Nowoczesne metody leczenia PBL
A. Immunoterapia – zastosowanie przeciwciał monoklonalnych
Immunoterapia stosowana w leczeniu Przewlekłej białaczki limfocytowej (PBL) wykorzystuje przeciwciała monoklonalne, które są zaprojektowane do celowania konkretnych białek na powierzchni komórek nowotworowych. Przykłady przeciwciał monoklonalnych stosowanych w leczeniu PBL to Rituximab, Obinutuzumab, czy Ofatumumab. Te leki mogą pomóc w niszczeniu komórek nowotworowych oraz wzmocnieniu reakcji układu odpornościowego przeciwko nowotworowi.
B. Terapie celowane – inhibitory kinaz tyrozynowych
Inhibitory kinaz tyrozynowych to grupa leków, które mogą być stosowane w leczeniu PBL w celu blokowania aktywności kinaz tyrozynowych, które odgrywają rolę w wzroście i podziałach komórek nowotworowych. Przykładem inhibitora kinazy tyrozynowej stosowanego w PBL jest Ibrutinib, który blokuje kinazę Brutona (BTK), prowadząc do zahamowania proliferacji komórek białaczki limfocytowej.
C. Przeszczepienie szpiku – kiedy jest konieczne?
Przeszczepienie szpiku kostnego (szpiku lub komórek krwiotwórczych) może być rozważane u pacjentów z Przewlekłą białaczką limfocytową (PBL) w zaawansowanych stadiach choroby lub u pacjentów, którzy nie uzyskali odpowiedzi na inne formy terapii. W niektórych przypadkach przeszczepienie szpiku może być jedyną szansą na wyleczenie PBL.
Procedura ta polega na zniszczeniu szpiku pacjenta za pomocą radioterapii lub chemioterapii, a następnie przeszczepieniu zdrowych komórek krwiotwórczych od dawcy do organizmu pacjenta. Przeszczepienie szpiku niesie za sobą ryzyko powikłań, dlatego decyzja o jego zastosowaniu jest podejmowana przez zespół lekarzy pod kątem korzyści i ryzyka dla pacjenta.
X. Leczenie wspomagające i paliatywne
A. Jak radzić sobie z objawami choroby?
Objawy Przewlekłej białaczki limfocytowej (PBL) mogą obejmować zmęczenie, utratę masy ciała, powiększone węzły chłonne, zwiększoną podatność na infekcje, gorączkę oraz zwiększone krwawienia i siniaki. Radzenie sobie z tymi objawami może wymagać zmiany stylu życia, w tym odpowiedniego zarządzania stresem, regularnej aktywności fizycznej, dbania o higienę osobistą i unikania potencjalnych źródeł infekcji. Ponadto, regularne wizyty lekarskie i regularne badania krwi są kluczowe dla monitorowania stanu zdrowia i odpowiedniego dostosowania terapii.
B. Wsparcie dietetyczne i suplementacja
- W przypadku Przewlekłej białaczki limfocytowej (PBL), właściwa dieta może odgrywać istotną rolę w radzeniu sobie z chorobą.
- Wsparcie dietetyczne może obejmować zbilansowaną dietę bogatą w warzywa, owoce, pełnoziarniste produkty zbożowe oraz zdrowe tłuszcze, a także unikanie żywności wysoko przetworzonej, bogatej w cukier i tłuszcze trans.
- Ponadto, może być konieczne stosowanie suplementów diety, takich jak witaminy i minerały, w celu uzupełnienia niedoborów wynikających z choroby lub związanych z leczeniem.
C. Rola fizjoterapii i aktywności fizycznej
Fizjoterapia może odgrywać ważną rolę w leczeniu wspomagającym Przewlekłej białaczki limfocytowej. Wsparcie fizjoterapeuty może pomóc pacjentom w zachowaniu lub poprawie sprawności fizycznej, redukcji bólu, radzeniu sobie z powiększonymi węzłami chłonnymi oraz zachęcaniu do aktywności fizycznej dostosowanej do indywidualnych możliwości i stanu zdrowia. Regularna aktywność fizyczna może przyczynić się do ogólnego lepszego samopoczucia, poprawy jakości snu oraz poprawy zdrowia psychicznego i emocjonalnego pacjenta.
XI. Życie z PBL – codzienne wyzwania
A. Jak zmienić styl życia po diagnozie?
Po diagnozie Przewlekłej białaczki limfocytowej (PBL) może być konieczne dostosowanie stylu życia aby radzić sobie z chorobą. To może obejmować modyfikację aktywności fizycznej z zachowaniem umiaru, unikanie stresu i realizację regularnych kontroli medycznych. Ważne jest także utrzymanie zbilansowanej diety oraz regularne spożywanie leków przepisanych przez lekarza. Zmiana stylu życia może wymagać wsparcia rodziny, przyjaciół i specjalistów, aby dostosować codzienne rutyny do nowych potrzeb zdrowotnych.
B. Wsparcie psychologiczne dla pacjentów i rodzin
PBL wiąże się z wieloma wyzwaniami emocjonalnymi zarówno dla pacjentów, jak i ich rodzin. Po diagnozie ważne jest zapewnienie wsparcia psychologicznego, które może pomóc w radzeniu sobie z lękiem, depresją, czy stresem. Wsparcie to może obejmować zarówno wsparcie terapeutyczne dla pacjenta jak i dla jego bliskich. Terapia behawioralna, grupowe wsparcie lub psychoterapia mogą pomóc w radzeniu sobie z diagnozą choroby nowotworowej i jej wpływem na codzienne życie.
C. Znaczenie grup wsparcia i organizacji pacjenckich
Grupy wsparcia oraz organizacje pacjenckie odgrywają ważną rolę w życiu z PBL. Udział w grupach wsparcia może zapewnić pacjentom możliwość spotkania innych osób, które przeżywają podobne doświadczenia oraz dzielenie się wiedzą i strategiami radzenia sobie z chorobą. Organizacje pacjenckie mogą zapewnić dostęp do wiedzy o chorobie, dostarczyć praktyczne wsparcie, informacje o nowych badaniach klinicznych oraz edukację na temat zarządzania chorobą. Działanie tych grup może również pomóc w zwiększeniu świadomości społecznej na temat PBL.
XII. Wpływ PBL na układ odpornościowy
A. Osłabienie odporności i podatność na infekcje
Pacjenci z Przewlekłą białaczką limfocytową (PBL) mogą doświadczać osłabienia ich układu odpornościowego. Wzrost liczby limfocytów białaczkowych w organizmie może wpłynąć na zdolność organizmu do zwalczania infekcji. Osłabiony układ odpornościowy może sprawić, że pacjenci są bardziej podatni na infekcje bakteryjne, wirusowe czy grzybicze. Dlatego też ważne jest, aby pacjenci z PBL regularnie monitorowali swój stan zdrowia i współpracowali z zespołem medycznym, aby odpowiednio reagować na pojawiające się infekcje.
B. Zalecenia dotyczące szczepień
Ze względu na osłabiony układ odpornościowy, pacjenci z PBL powinni podążać za zaleceniami dotyczącymi szczepień. Szczepienia mogą pomóc w ochronie przed infekcjami, które mogą być szczególnie niebezpieczne dla osób z osłabioną odpornością. Doradzenie się z lekarzem lub hematologiem w celu określenia odpowiednich szczepień i harmonogramu szczepień jest kluczowe. Ważne jest również unikanie szczepień wykonawczych, takich jak szczepienia na żywe drobnoustroje, które mogą stanowić ryzyko dla osób z osłabionym układem odpornościowym.
C. Profilaktyka infekcji u pacjentów z PBL
Aby zminimalizować ryzyko infekcji u pacjentów z Przewlekłą białaczką limfocytową, istotna jest profilaktyka infekcyjna. Pacjenci powinni stosować zalecenia higieniczne, takie jak regularne mycie rąk, unikanie kontaktu z osobami chorymi, czy unikanie zatłoczonych miejsc w okresach wzmożonej aktywności wirusów. Dodatkowo, pacjenci powinni unikać surowych pokarmów i żywności niewłaściwie przechowywanej lub zanieczyszczonej, które mogą prowadzić do zakażeń pokarmowych. Utrzymywanie zdrowego stylu życia, regularne zażywanie leków na receptę i współpraca z zespołem medycznym mogą pomóc w zapobieganiu infekcjom oraz utrzymaniu dobrego stanu zdrowia.
XIII. PBL a inne choroby przewlekłe
A. Współwystępowanie z innymi nowotworami
Pacjenci z Przewlekłą białaczką limfocytową (PBL) mogą być bardziej podatni na współwystępowanie z innymi nowotworami. Badania wykazały, że osoby z PBL mogą mieć zwiększone ryzyko wystąpienia innych nowotworów, takich jak chłoniaki nie-Hodgkina, białaczki innej niż PBL, czy inne nowotwory złośliwe. Dlatego ważne jest regularne monitorowanie pacjentów z PBL pod względem możliwych nowotworów oraz ścisła współpraca z zespołem medycznym w celu skutecznej diagnostyki i leczenia.
B. PBL a choroby autoimmunologiczne
Istnieje również związek między PBL a chorobami autoimmunologicznymi, które mogą współistnieć u pacjentów. Choroby autoimmunologiczne, takie jak reumatoidalne zapalenie stawów, toczeń układowy, czy niedokrwistość hemolityczną, mogą występować równocześnie z PBL. Jest to wynikiem zaburzeń w układzie odpornościowym, które prowadzą zarówno do rozwoju PBL, jak i chorób autoimmunologicznych. Konieczne jest monitorowanie pacjentów z PBL pod kątem objawów lub współistnienia chorób autoimmunologicznych oraz opracowanie odpowiednich strategii leczenia i opieki koordynowanej.
C. Interakcje leków stosowanych w leczeniu
Pacjenci z PBL mogą być leczeni różnymi lekami, zarówno na PBL, jak i na inne choroby współistniejące. Istnieje ryzyko interakcji między lekami, które mogą być stosowane równocześnie. Dlatego ważne jest, aby pacjenci informowali swoich lekarzy o wszystkich przyjmowanych lekach, włącznie z lekami na receptę, suplementami diety oraz lekami dostępnymi bez recepty. Podczas leczenia PBL i innych chorób przewlekłych, monitorowanie interakcji leków i dostosowywanie terapii farmakologicznej jest kluczowe dla zapewnienia skutecznego i bezpiecznego leczenia.
XIV. Badania naukowe i przyszłość leczenia
A. Najnowsze odkrycia w terapii PBL
Najnowsze badania naukowe nad Przewlekłą białaczką limfocytową (PBL) skupiają się na poszukiwaniu nowych terapii, które mogą być skuteczniejsze i bardziej ukierunkowane na leczenie tej choroby. Odkrycia naukowe obejmują rozwój terapii celowanych, takich jak leki przeciwciał monoklonalnych czy terapie immunologiczne, które mogą pomóc w zwalczaniu komórek nowotworowych PBL. Badania nad biomarkerami predykcyjnymi mogą również pomóc w określeniu najlepszego dostosowanego leczenia dla pacjentów.
B. Badania kliniczne – jak wziąć udział?
Osoby z PBL mogą mieć możliwość wzięcia udziału w badaniach klinicznych, które są przeprowadzane w celu oceny skuteczności nowych terapii oraz lepszego zrozumienia tej choroby. Pacjenci zainteresowani udziałem w badaniach klinicznych powinni skonsultować się ze swoim lekarzem, który może pomóc w znalezieniu odpowiedniego programu badawczego oraz omówieniu potencjalnych korzyści i ryzyka związanego z udziałem. Udział w badaniach klinicznych może przynieść korzyści nie tylko pacjentom, ale również przyczynić się do postępu w leczeniu PBL dla przyszłych pacjentów.
C. Perspektywy leczenia w najbliższych latach
Perspektywy leczenia Przewlekłej białaczki limfocytowej w najbliższych latach wydają się obiecujące ze względu na rozwój terapii celowanych i coraz bardziej spersonalizowanego podejścia do leczenia. Dalsze badania naukowe i postępy technologiczne mogą doprowadzić do wprowadzenia nowych, skuteczniejszych terapii oraz poprawy jakości życia pacjentów z PBL. Perspektywy obejmują również rozwój terapii kombinowanych oraz dalsze zrozumienie mechanizmów patofizjologicznych odpowiedzialnych za rozwój PBL. Wraz z postępem nauki i przeprowadzanymi badaniami można oczekiwać lepszych i bardziej innowacyjnych metod leczenia tej choroby w przyszłości.
XV. PBL a jakość życia
A. Jak radzić sobie ze zmęczeniem?
Zmęczenie jest powszechnym problemem u osób cierpiących na Przewlekłą białaczkę limfocytową (PBL). Aby radzić sobie ze zmęczeniem, ważne jest dbanie o odpowiednią dietę, aktywność fizyczną w miarę możliwości, odpowiednią ilość snu oraz stosowanie technik relaksacyjnych. Pacjenci mogą również skorzystać z pomocy specjalistów, takich jak terapeuta zajęciowy czy psycholog, aby opracować indywidualne strategie radzenia sobie z zmęczeniem.
B. Czy można prowadzić aktywne życie zawodowe?
Osoby z Przewlekłą białaczką limfocytową mogą prowadzić aktywne życie zawodowe, pod warunkiem odpowiedniego zarządzania swoim stanem zdrowia. Ważne jest komunikowanie się z pracodawcą, aby dostosować harmonogram pracy do możliwości pacjenta, a także korzystanie z dostępnych środków wsparcia, takich jak urlopy zdrowotne czy elastyczne godziny pracy. Organizowanie czasu, odpoczynek i dbanie o równowagę między pracą a odpoczynkiem są kluczowe dla utrzymania aktywnego życia zawodowego.
C. Strategie radzenia sobie ze stresem i depresją
Przewlekła choroba, taką jak Przewlekła białaczka limfocytowa, może być powodem stresu i depresji u pacjentów. Ważne jest stosowanie strategii radzenia sobie ze stresem, takich jak medytacja, relaksacja, regularna aktywność fizyczna, wsparcie psychologiczne oraz rozmowy z bliskimi. Pacjenci mogą skorzystać z terapii psychologicznej lub grup wsparcia, gdzie mogą dzielić się swoimi uczuciami i doświadczeniami. Poprawa zdrowia psychicznego może przyczynić się do poprawy jakości życia pacjentów z PBL oraz zmniejszenia negatywnych skutków występowania stresu i depresji.
XVI. Dieta i suplementacja przy PBL
A. Jakie produkty wspierają układ odpornościowy?
Produkty, które mogą wspierać układ odpornościowy u osób z Przewlekłą białaczką limfocytową, obejmują:
- Żywność bogatą w przeciwutleniacze, takie jak owoce jagodowe (np. jagody, borówki, maliny), warzywa liściaste (np. szpinak, jarmuż, boćwina) oraz czerwona kapusta.
- Produkty bogate w witaminę C, takie jak cytrusy, kiwi, papryka, brokuły.
- Żywność zawierającą cynk, np. orzechy, pestki dyni, mięso, jaja.
B. Czy dieta może pomóc w leczeniu PBL?
Dieta może wspomagać leczenie i zarządzanie Przewlekłą białaczką limfocytową poprzez dostarczanie składników odżywczych, które wspierają układ odpornościowy i mają korzystny wpływ na ogólną kondycję organizmu. Dieta bogata w świeże owoce, warzywa, pełnoziarniste produkty zbożowe, zdrowe tłuszcze (np. awokado, orzechy, oliwa z oliwek) oraz białko pochodzenia roślinnego lub niskotłuszczowe białko zwierzęce może pomóc w utrzymaniu dobrej kondycji zdrowotnej.
C. Suplementy diety – które warto stosować?
Osoby z Przewlekłą białaczką limfocytową mogą rozważyć stosowanie suplementów diety po konsultacji z lekarzem. Niektóre suplementy, które mogą być brane pod uwagę, to:
- Witamina D, która odgrywa rolę w funkcjonowaniu układu immunologicznego.
- Omegi-3 (np. z oleju rybiego), które mogą mieć działanie przeciwzapalne i korzystny wpływ na układ sercowo-naczyniowy.
- Probiotyki, które korzystnie wpływają na mikrobiotę jelitową i mogą wspomagać zdrowie układu pokarmowego.
Pamiętaj, że decyzja o stosowaniu suplementów diety powinna być podejmowana we współpracy z lekarzem, uwzględniając indywidualne potrzeby zdrowotne i potencjalne interakcje z innymi lekami.
XVII. Wsparcie dla pacjentów i rodzin
A. Jak przygotować się na różne etapy choroby?
Przygotowanie się na różne etapy Przewlekłej białaczki limfocytowej może obejmować:
- Edukację na temat choroby: zrozumienie symptomy, przebieg choroby, plan leczenia i możliwe skutki uboczne.
- Regularne kontrole lekarskie: ważne jest regularne monitorowanie stanu zdrowia pod nadzorem specjalistów.
- Utrzymywanie zdrowego stylu życia: dieta bogata w składniki odżywcze, regularna aktywność fizyczna, odpowiedni sen.
- Ustalenie strategii radzenia sobie z emocjami: ważne jest rozmawianie z terapeutą lub psychologiem, a także korzystanie z wsparcia grupy wsparcia dla osób z podobną chorobą.
B. Gdzie szukać pomocy i informacji?
Pomoc i informacje na temat Przewlekłej białaczki limfocytowej można znaleźć w następujących miejscach:
- U specjalistów medycznych: hematologów, onkologów, pielęgniarek specjalistycznych.
- W organizacjach pacjenckich: grupach wsparcia dla osób z rakiem krwi, fundacjach zajmujących się badaniami nad białaczką.
- W literaturze medycznej i na stronach internetowych renomowanych instytucji medycznych.
C. Rola bliskich w procesie leczenia
Bliscy osób z Przewlekłą białaczką limfocytową odgrywają istotną rolę w procesie leczenia poprzez udzielenie wsparcia emocjonalnego, fizycznego i praktycznego. Ich zaangażowanie może być kluczowe dla dobrego samopoczucia pacjenta. Bliscy mogą pomagać w organizacji wizyt lekarskich, wspieraniu w zachowaniu zdrowego stylu życia, słuchaniu i zrozumieniu potrzeb chorego. Ważne jest również otwarte komunikowanie się i budowanie zaufania między pacjentem a jego bliskimi, aby mogli wspólnie przetrwać trudne chwile i radzić sobie z wyzwaniami związanymi z chorobą.
XVIII. Mity i fakty na temat PBL
A. Najczęstsze nieporozumienia dotyczące choroby
Najczęstsze nieporozumienia dotyczące Przewlekłej białaczki limfocytowej to między innymi:
- Myśl, że białaczka jest zawsze chorobą śmiertelną – w rzeczywistości przebieg choroby może być różny, a wielu pacjentów żyje z nią przez wiele lat.
- Myśl, że wszystkie białaczki limfocytowe są takie same – istnieje wiele różnych typów białaczek limfocytowych, a Przewlekła białaczka limfocytowa ma specyficzne cechy i leczenie.
- Myśl, że objawy białaczki zawsze są natychmiastowe i dramatyczne – często objawy są subtelne i stopniowo nasilające się.
B. Czy PBL zawsze prowadzi do śmierci?
Przewlekła białaczka limfocytowa nie zawsze prowadzi do śmierci. W rzeczywistości, wiele osób żyje z tą chorobą przez wiele lat, kontrolując ją za pomocą leczenia i regularnych kontroli medycznych. Długoterminowe prognozy dla pacjentów z PBL mogą być różne i zależą od wielu czynników, takich jak wiek pacjenta, stadium choroby, reakcja na leczenie i obecność innych schorzeń.
C. Fakty naukowe kontra popularne przekonania
Kilka faktów naukowych kontra popularne przekonania na temat Przewlekłej białaczki limfocytowej to:
- Fakty: Przewlekła białaczka limfocytowa to typ raka krwi, w którym dochodzi do nadmiernego wzrostu limfocytów. Jest to powolny rozwijający się nowotwór.
- Prawdziwe: Rozwój białaczki limfocytowej nie zawsze prowadzi do szybkiego pogorszenia stanu zdrowia.
- Fakty: Istnieją skuteczne metody leczenia, które mogą zapewnić kontrolę choroby i poprawę jakości życia pacjentów.
Zrozumienie faktów naukowych związanych z Przewlekłą białaczką limfocytową może pomóc w obaleniu powszechnych mitów i zwiększeniu świadomości na temat tej choroby rakowej. Warto korzystać z rzetelnych źródeł informacji oraz konsultować się z specjalistami medycznymi, aby uniknąć dezinformacji i zrozumieć prawdziwy obraz tej choroby.
XIX. Podsumowanie
A. Kluczowe informacje o PBL
- Przewlekła białaczka limfocytowa (PBL) to rodzaj raka krwi, w którym dochodzi do nadmiernego wzrostu limfocytów, specyficznego typu białych krwinek.
- Choroba ta charakteryzuje się powolnym przebiegiem i może długo pozostawać bezobjawowa.
- Diagnoza PBL wymaga specjalistycznych badań krwi i innych testów diagnostycznych.
- Istnieją różne typy PBL, a leczenie może obejmować obserwację, leki, terapie celowane oraz przeszczep szpiku kostnego.
B. Najważniejsze wnioski dla pacjentów i ich rodzin
- Dla pacjentów i ich rodzin kluczowe jest zrozumienie, że Przewlekła białaczka limfocytowa to choroba przewlekła, ale nie zawsze prowadzi do śmierci.
- Ważne jest regularne monitorowanie stanu zdrowia, zgodność z zaleceniami lekarskimi oraz regularne kontrole u specjalistów.
- Wsparcie emocjonalne i psychologiczne dla pacjentów i ich rodzin jest także istotne w procesie leczenia PBL.
C. Znaczenie wczesnej diagnozy i odpowiedniego leczenia
- Wczesna diagnoza Przewlekłej białaczki limfocytowej ma kluczowe znaczenie dla skutecznego leczenia i kontrolowania choroby.
- Regularne badania krwi, wizyty kontrolne u lekarza hematologa oraz świadomość objawów mogą pomóc w szybkiej identyfikacji choroby.
- Wczesne i skuteczne leczenie, dostosowane do indywidualnych potrzeb pacjenta, może zwiększyć szansę na poprawę jakości życia oraz dłuższe przeżycie bez powikłań związanych z PBL.
XX. Najczęściej zadawane pytania (FAQ)
A. Czy PBL można wyleczyć?
Przewlekła białaczka limfocytowa zwykle nie ulega całkowitemu wyleczeniu. Choroba charakteryzuje się przewlekłym przebiegiem, a celem leczenia jest kontrola nad chorobą, spowolnienie postępu oraz poprawa jakości życia pacjenta. Istnieją terapie, które mogą przynieść remisję lub kontrolować objawy, ale całkowite wyleczenie nie jest częste.
B. Jakie są pierwsze symptomy, na które należy zwrócić uwagę?
Najczęstsze objawy Przewlekłej białaczki limfocytowej to powiększone węzły chłonne, przewlekłe zmęczenie, gorączka, utrata masy ciała, nadmierna potliwość i infekcje. Jeśli pacjent doświadcza takich objawów, należy skonsultować się z lekarzem w celu dalszej diagnostyki.
C. Czy przewlekła białaczka limfocytowa jest dziedziczna?
Przewlekła białaczka limfocytowa nie jest typowo dziedziczna. Większość przypadków PBL nie jest związana z czynnikami genetycznymi. Istnieją jednak rzadkie przypadki, w których choroba może występować rodzinie, co sugeruje warunki genetyczne jako czynnik ryzyka.
D. Jak długo można żyć z PBL bez leczenia?
Przewlekła białaczka limfocytowa rozwija się powoli i może przebiegać długo bezobjawowo. Okres przeżycia bez leczenia może być zmienny i zależy od indywidualnego przypadku, postępu choroby i obecności ewentualnych współistniejących schorzeń.
E. Jakie są najnowsze metody terapii?
Najnowsze metody terapii dla Przewlekłej białaczki limfocytowej obejmują terapie celowane, immunoterapię, leki przeciwciał monoklonalnych oraz terapie oparte na przeszczepach komórkowych. Badania nad nowymi lekami i terapiami są ciągle prowadzone, aby zapewnić pacjentom lepsze i skuteczniejsze opcje terapeutyczne.
Zioła w leczeniu chorób: Przewlekła białaczka limfocytowa
Należy pamiętać, że leczenie Przewlekłej białaczki limfocytowej powinno być prowadzone pod ścisłą kontrolą lekarza specjalisty. Nie ma jednoznacznych dowodów na skuteczność ziół w leczeniu tego schorzenia, ale istnieją zioła, które mogą wspomagać ogólne zdrowie i system immunologiczny. Zioła, które często są wspomniane w kontekście poprawy odporności i jako uzupełnienie leczenia, to m.in.:
- Echinacea: Zioło znane ze swoich właściwości wzmacniających układ odpornościowy.
- Astragalus: Powszechnie stosowany w medycynie chińskiej jako środek wspierający odporność.
- Kurkuma: Znana z działania przeciwzapalnego i przeciwnowotworowego; może być korzystna dla osób z przewlekłymi stanami zapalnymi.
- Miłek wąskolistny: Często stosowany w krajach azjatyckich jako adaptogen (poprawiający zdolność organizmu do radzenia sobie ze stresem).
Pamiętaj, że zawsze należy skonsultować się z lekarzem przed rozpoczęciem suplementacji ziół w przypadku Przewlekłej białaczki limfocytowej, aby uniknąć potencjalnych interakcji z lekami przeciwbiałaczkowymi lub innymi środkami terapeutycznymi.